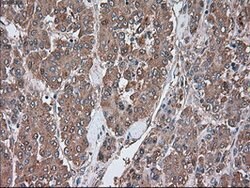
SERPINA1 Mouse anti-Canine, Human, Clone: OTI9A1, lyophilized, TrueMAB

Learn More
SERPINA1 Mouse anti-Canine, Human, Clone: OTI9A1, lyophilized, TrueMAB™
Mouse Monoclonal Antibody
Brand: Origene Technologies CF500374

Description
Reconstitute with PBS (pH 7.3) and recommend to perform another round of desalting process using Product No. 7KMWCO
Alpha-1-AT is synthesized in the liver and it acts as an inhibitor of proteases such as trypsin, elastase, chymotrypsin, collagenase, leucocytic proteases, plasmin, and thrombin, which may be released during inflammatory reactions in the lung. In the absence of alpha-1-AT, these enzymes are not inhibited and they may digest pulmonary parenchyma. Alpha-1-AT deficiency is associated with chronic obstructive lung disease (emphysema) and less frequently with hepatic cirrhosis in infants and respiratory distress of the newborn. Increase in alpha-1-AT occurs as an acute phase response to tissue necrosis and inflammation. Serum level of alpha-1-AT is elevated in rheumatoid arthritis, bacterial infections, vasculitis, and carcinomatosis.Specifications
| SERPINA1 | |
| Monoclonal | |
| Unconjugated | |
| SERPINA1 | |
| A1A, A1AT, AAT, PI, PI1, PRO2275, alpha1AT, nNIF | |
| Mouse | |
| Affinity Chromatography | |
| RUO | |
| 480422, 5265 | |
| -20° C, Avoid Freeze/Thaw Cycles | |
| Lyophilized |
| Flow Cytometry, Immunohistochemistry (Paraffin), Immunoprecipitation, Western Blot | |
| OTI9A1 | |
| PBS with 8% trehalose and no preservative; pH 7.3 | |
| P01009 | |
| SERPINA1 | |
| Full-length protein expressed in 293T cell transfected with human SERPINA1 expression vector | |
| 100 μg | |
| Primary | |
| Canine, Human | |
| Antibody | |
| IgG1 |
The Fisher Scientific Encompass Program offers items which are not part of our distribution portfolio. These products typically do not have pictures or detailed descriptions. However, we are committed to improving your shopping experience. Please use the form below to provide feedback related to the content on this product.